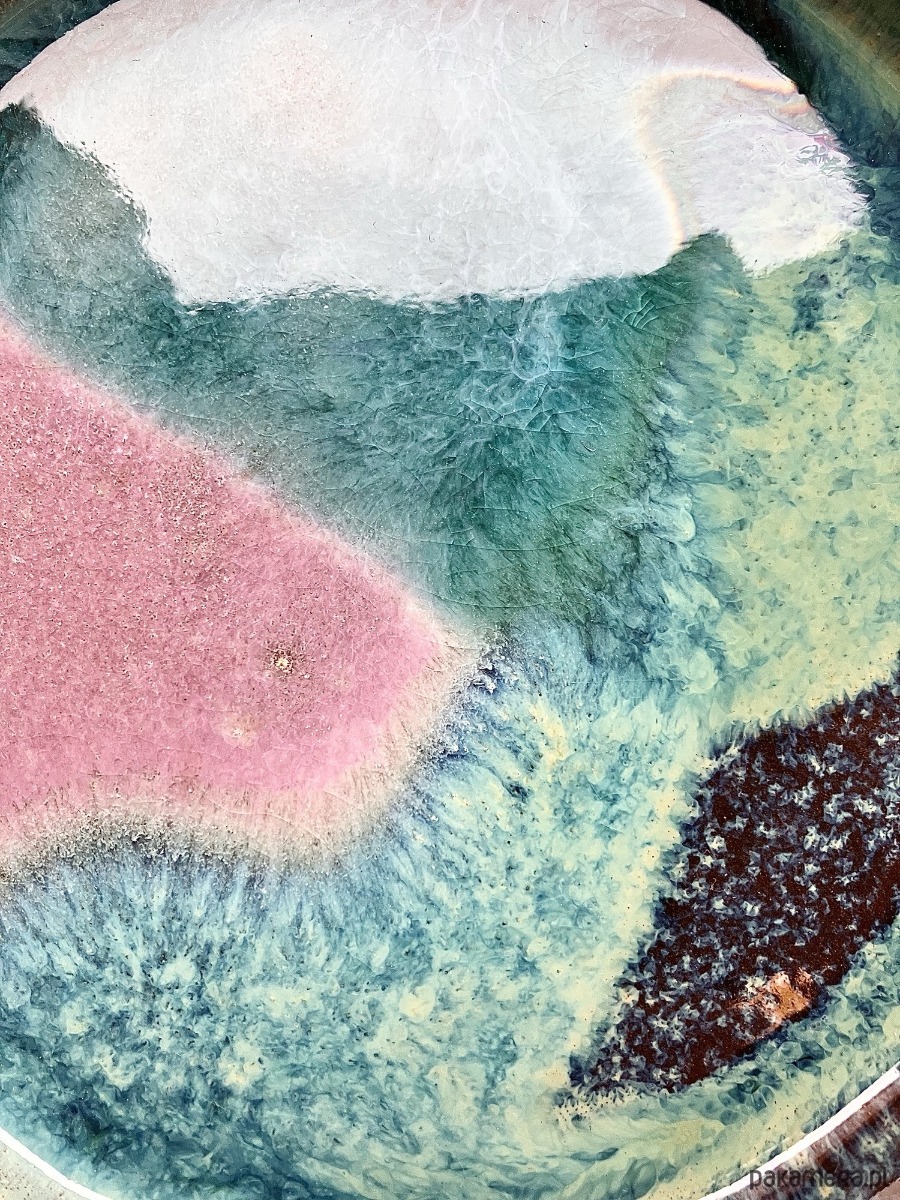

Talerzyk *Organic* 15cm
Studio MGart
80,00 zł
Ulubione
Rób zakupy w Pakamerze i odbierz rabat
- Za każde 1 zł wydane w Pakamerze przekazujemy na twoje konto 1 punkt.
- Po zgromadzeniu punktów możesz odebrać rabat na nieograniczony ilościowo zakup :)
Dołącz do Klubu Rabatowego i zacznij zbierać punkty.
ZOBACZ
Szczegóły
TALERZYK *ORGANIC* z rantem. Głębokie odcienie turkusu tworzą bazę przełamaną akcentami fioletu i granatu, które nadają naczyniu wyjątkowego charakteru inspirowanego naturą. Doskonały wybór dla miłośników naturalnych kolorów i elegancji. Sprawdzi się do podawania deserów, przekąsek lub na twoją ukochaną biżuterię.
Wymiary talerzyka:
● średnica ✿ 15 cm
Każdy talerzyk może różnić się delikatnie we wzorach i kolorach, gdyż produkty wyrabiam oraz szkliwię ręcznie. To w ceramice kocham najmocniej – wszystko ma swoją oryginalność i niepowtarzalność.
Talerzyki można myć w zmywarce oraz używać w kuchence mikrofalowej. Szkliwa, z których korzystamy są bez ołowiowe. Oznacza to, że wszystkie nasze naczynia przeznaczone są do kontaktu z żywnością.
Wymiary talerzyka:
● średnica ✿ 15 cm
Każdy talerzyk może różnić się delikatnie we wzorach i kolorach, gdyż produkty wyrabiam oraz szkliwię ręcznie. To w ceramice kocham najmocniej – wszystko ma swoją oryginalność i niepowtarzalność.
Talerzyki można myć w zmywarce oraz używać w kuchence mikrofalowej. Szkliwa, z których korzystamy są bez ołowiowe. Oznacza to, że wszystkie nasze naczynia przeznaczone są do kontaktu z żywnością.
Nr przedmiotu : 4114171
Dostawa i płatność
Metody płatności
Dostawa
Termin realizacji zamówienia to 3-4 dni roboczych.
Wysyłka z kraju : Polska
- przelew bankowy lub wpłata na Poczcie - płatność z góry

- szybki przelew z PayU
- konto PayPal
- karta płatnicza / kredytowa
- Zapłać później
- Zakup na raty - PayU

Dostawa
Termin realizacji zamówienia to 3-4 dni roboczych.
Wysyłka z kraju : Polska
Zwroty i reklamacje
Projektant gwarantuje, że oferowany produkt jest wolny od wad.
Zwroty
Możesz zwrócić zakupiony produkt bez podania przyczyny w przeciągu 14 dni od daty jego otrzymania. Wystarczy, że wyślesz wiadomość e-mail na adres Pakamery. Pamiętaj, że produkt musi być w stanie nienaruszonym i nie może nosić śladów używania. Zwracany towar przesyłasz na własny koszt wraz z wypełnionym formularzem o odstąpieniu od umowy (do pobrania po zalogowaniu). Produkty wykonane na indywidualne zamówienie nie podlegają zwrotowi. Pełna procedura zwrotu (tutaj)
Reklamacje i rękojmia
Jeżeli po otrzymaniu produktu stwierdzisz w nim wady wyślij wiadomość e-mail na adres Pakamery. Niezwłocznie się z tobą skontaktujemy informując o dalszych krokach. Pełna procedura reklamacji (tutaj). Szczegółowe warunki rękojmi (tutaj)
Prawo konsumenta
Ten przedmiot wystawiła osoba prywatna. W związku z tym zakupy, które u niej robisz, nie są objęte przepisami konsumenckimi. W zakup przedmiotu lub zlecenie usługi na Pakamera.pl zaangażowanych jest kilka podmiotów. Każdy z nich ma następujące obowiązki. Pakamera.pl: pełni funkcję pośrednią, dostarczając rozwiązania techniczne umożliwające zawarcie umowy; przyjmuje i płatności od Kupujących; przekazuje dane dostawy podane przez Kupująceg Sprzedającemu; informuje Sprzedającego o konieczności dostawy; przyjmuje zgłoszenia zwrotów/reklamacji od Kupujących; dokonuje zwrotu środków Kupującemu na zlecenie Sprzedającego; może uczestniczyć w komunikacji z Kupującym. Do obowiązków Sprzedającego jako osoby prywatnej należy: wprowadzanie i wystawianie ofert na Pakamera; dostawa złożonych zamówień; komunikacja z Kupującym; uznawanie/odrzucanie zwrotów; przyjmowanie fizycznych zwrotów; potwierdzanie otrzymania zwrotu. Partner płatności: jest odpowiedzialny za zapewnienie metody płatności online, a partnerzy logistyczni zajmujący się dostawą są odpowiedzialni za dostarczenie przedmiotów do Kupującego, jak opisano w ich Regulaminach.
Osoba odpowiedzialna, producent
Zwroty
Możesz zwrócić zakupiony produkt bez podania przyczyny w przeciągu 14 dni od daty jego otrzymania. Wystarczy, że wyślesz wiadomość e-mail na adres Pakamery. Pamiętaj, że produkt musi być w stanie nienaruszonym i nie może nosić śladów używania. Zwracany towar przesyłasz na własny koszt wraz z wypełnionym formularzem o odstąpieniu od umowy (do pobrania po zalogowaniu). Produkty wykonane na indywidualne zamówienie nie podlegają zwrotowi. Pełna procedura zwrotu (tutaj)
Reklamacje i rękojmia
Jeżeli po otrzymaniu produktu stwierdzisz w nim wady wyślij wiadomość e-mail na adres Pakamery. Niezwłocznie się z tobą skontaktujemy informując o dalszych krokach. Pełna procedura reklamacji (tutaj). Szczegółowe warunki rękojmi (tutaj)
Prawo konsumenta
Ten przedmiot wystawiła osoba prywatna. W związku z tym zakupy, które u niej robisz, nie są objęte przepisami konsumenckimi. W zakup przedmiotu lub zlecenie usługi na Pakamera.pl zaangażowanych jest kilka podmiotów. Każdy z nich ma następujące obowiązki. Pakamera.pl: pełni funkcję pośrednią, dostarczając rozwiązania techniczne umożliwające zawarcie umowy; przyjmuje i płatności od Kupujących; przekazuje dane dostawy podane przez Kupująceg Sprzedającemu; informuje Sprzedającego o konieczności dostawy; przyjmuje zgłoszenia zwrotów/reklamacji od Kupujących; dokonuje zwrotu środków Kupującemu na zlecenie Sprzedającego; może uczestniczyć w komunikacji z Kupującym. Do obowiązków Sprzedającego jako osoby prywatnej należy: wprowadzanie i wystawianie ofert na Pakamera; dostawa złożonych zamówień; komunikacja z Kupującym; uznawanie/odrzucanie zwrotów; przyjmowanie fizycznych zwrotów; potwierdzanie otrzymania zwrotu. Partner płatności: jest odpowiedzialny za zapewnienie metody płatności online, a partnerzy logistyczni zajmujący się dostawą są odpowiedzialni za dostarczenie przedmiotów do Kupującego, jak opisano w ich Regulaminach.
Osoba odpowiedzialna, producent
pokaż szczegóły